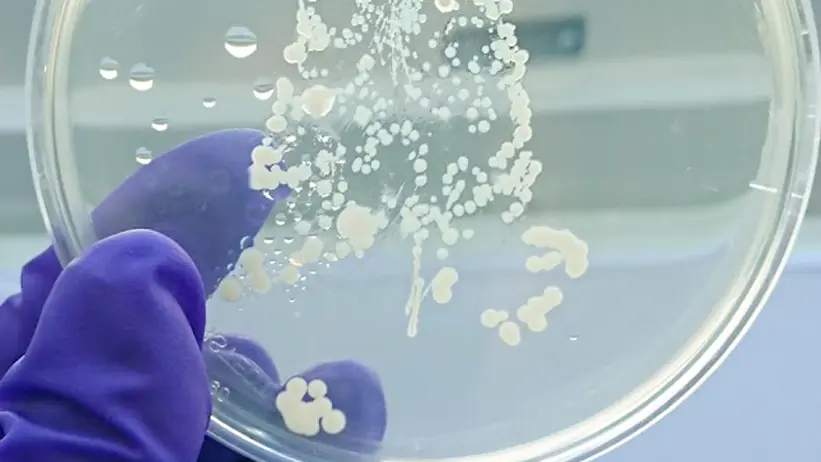

Olika våglängder av ljus kan ge bättre växtskydd
Växtytor är inte alltid en gästvänlig miljö för nyttiga bakterier som hjälper till att skydda växter mot skadegörare. I en ny doktorsavhandling har Maria Hellström undersökt hur olika våglängder av ljus kan hjälpa bakterierna, både i lab- och växthusmiljö.
För att odla hälsosamma grödor utan att skada miljön behöver vi minska användningen av kemiska bekämpningsmedel. Ett alternativ är att använda nyttiga bakterier som biologiska bekämpningsmedel. De här bakterierna kan skydda växterna genom att producera ämnen som stör eller dödar skadegörare eller helt enkelt tar upp plats så skadegörarna inte får fäste på växten.
Vissa våglängder påverkar bakterier
Men det finns en utmaning – växtytor är inte alltid en gästvänlig miljö för bakterier. För att göra nytta måste bakterierna kunna fästa på bladen, överleva konkurrensen från andra mikroorganismer och föröka sig.
– Här kommer en oväntad hjälpare in i bilden: ljus! Trots att många bakterier inte använder ljus som energikälla kan vissa ljusvåglängder ändå påverkar deras beteende. En del bakterier kan till exempel bilda skyddande biofilmer eller producera ämnen som hjälper dem att överleva längre, berättar Maria Hellström.
I sin doktorsavhandling har Maria testat hur tre olika nyttiga bakterier reagerade på synligt ljus i både laboratorium och växthusmiljö.
– I laboratoriet var det två av bakterierna, Bacillus amyloliquefaciens och Pseudomonas chlororaphis, trivdes bäst under blått ljus, medan Streptomyces griseoviridis föredrog rött ljus. I växthuset överlevde alla bakterier längst i grönt och vitt ljus och S. griseoviridis klarade sig bra oavsett ljusförhållanden. Däremot ogillade B. amyloliquefaciens rött ljus.
Ljussättning - en framtida komponent i hållbar växthusodling
Det fanns alltså ingen universallösning – ljusets effekt berodde på bakterietyp och miljö.
– Men det är spännande att vi genom att kombinera biologisk bekämpning med ljusstyrning kan utveckla nya växtskyddsstrategier. Genom att förstå hur ljus påverkar nyttiga bakterier kan vi kanske en dag använda belysning som en del av ett mer hållbart odlingssystem i växthus.
Råd till växthusodlare
Har Maria några råd redan nu till växthusodlare när det kommer till ljussättning?
– Jag skulle rekommendera att om man använder sig av vitt ljus i sin odling är det bara att fortsätta, då vi såg att de tre biologiska bekämpningsorganismerna vi jobbade med överlevde bäst under fullspektrumljus. Både bakterierna och växterna verkade må som bäst under det vita ljuset men också under det gröna.
– I vårt fall var det ett ganska kallt vitt ljus, dvs. med flera toppar i det blåa spektrumet så det skulle kunna vara viktigt att kika på lamporna man har i växthuset för att se hur ljussammansättningen faktiskt är. Något man skulle kunna fundera på är att om man använder sig av längre perioder av monokromatiska ljusbehandlingar i sin odling att man skall kanske inte applicera biologiska bekämpningsmedel precis innan, då vi såg att de olika organismerna överlevde olika bra beroende på våglängden.
Att kombinera ljusbehandling med nyttig bakterie och skadegörare
Om Maria skulle fortsätta att forska i området skulle hon vilja ta reda på vad och hur mycket enskilda våglängder påverkar bakterier som inte själva använder ljus, vilka metaboliska funktioner som påverkas av behandlingen och om intensiteten spelar någon större roll.
– Vi har sett att ljuset kan inducera biofilmsformation men det skulle vara ännu mer intressant att få veta om man kan se en ökad eller minskad genuttryckspåverkan beroende på våglängden. Något mer som skulle vara både spännande och kul skulle vara att se om en kombination av ljusbehandlingen tillsammans med biologisk bekämpningsorganism och en skadegörare. Skulle man kunna hitta något som gynnar den nyttiga bakterien och växten men missgynnar skadegöraren? Det skulle vara kul att få kika på.
På jakt efter nästa äventyr
Nu är Maria på jakt efter sitt nästa äventyr och hon är öppen för det mesta.
– Drömjobbet hade varit att fortsätta forska på något sätt, antingen på ett universitet eller på ett företag. Det som just nu ligger nära mitt hjärta är hur olika ekologiska koncept skulle kunna appliceras i valet av nya biologiska preparat och hur vi kan använda oss av det för att förbättra deras effekt. Jag är intresserad av att fortsätta jobba med mikroorganismer men det är också intressant att fortsätta med växtsidan, avslutar Maria.
Kontakt
-
Person